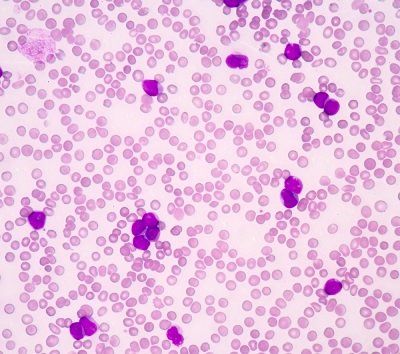

Findings from a study indicate that measurable residual disease clearance is associated with favorable outcomes in acute myeloid leukemia following subsequent therapy before allogenic stem cell transplant.
Certain molecular features such as cytogenetic abnormalities, genetic mutations, and clonal number before induction were predictive of measurable residual disease (MRD) clearance for acute myeloid leukemia (AML), according to findings from a study published in the American Journal of Hematology.
“Our data argue for future strategies tailored to patients with adverse molecular features and high clonal diversity who are currently unlikely to achieve AML MRD clearance,” according to the authors of a study published in the American Journal of Hematology.
Among patients who received induction chemotherapy, the MRD remission, MRD-positive remission, and persistent disease rate in 35% (n = 73/211), 27% (n = 58/211), and 38% (n = 80/211) of all patients with AML, respectively. Investigators noted a trend towards improved overall survival (OS) for patients with 2017 European LeuekemiaNet (ELN)–adverse risk disease who had a MRD-negative remission following induction chemotherapy, although this was not statistically significant (P = .16).
Among 132 patients who received allogeneic stem transplant (allo-SCT), 34% achieved MRD-negative remission following 7+3 induction chemotherapy and 21% had persistent disease or an MRD-positive remission post-induction before achieving an MRD-negative remission prior to allo-SCT. Conversion from MRD-positive to MRD-negative remission primarily occurred through consolidation therapy in 75% of patients, intensive reinduction or non-intensive therapy in 10% of patients each, and maintenance therapy for 5% of patients.
Investigators of this study retrospectively assessed data including patients with AML who received induction chemotherapy with a 7-day continuous infusion of cytarabine and 3 days of anthracycline from April 2014 to March 2020.
Investigators evaluated responses to therapy based on the 2017 ELN response criteria modified by MRD status. MRD was determined through a multiparametric flow cytometry test of bone marrow aspirate samples with any level of residual disease being identified as MRD positive.
Patient responses were determined at 3 relevant clinical timepoints: following completion of induction chemotherapy, before allo-SCT, and after allo-SCT before any further line of therapy. Investigators performed cytogenetic and mutational analyses on bone marrow aspirate or peripheral blood samples prior to induction therapy.
Of the 211 total patients, 64% had de novo AML and 36% had secondary AML. Following induction therapy, 33% received consolidation therapy and 45% had intensive re-induction for persistent disease or salvage therapy for relapsed disease.
All patients with core-binding factor (CBF) leukemia achieved an MRD-negative remission with induction therapy. Additionally, MRD-negative remission rates were 58% (odds ratio [OR], 3.01; 95% CI, 1.29-6.97; P = .014) for those with NRAS mutations and 70% (OR, 4.78; 95% CI, 1.2-19.12; P = .034) for KRAS mutations following induction therapy.
No patients with TP53 or SF3B1 mutations had an MRD-negative remission before allo-SCT despite induction and post-induction therapy. Multivariate logistic regression demonstrated that TP53 and SF3B1 mutations remained statistically significantly associated with lower rates of MRD clearance rates prior to allo-SCT.
Patients who had MRD-negative remission after induction therapy had a lower number of clones (mean, 3.33; standard deviation [SD], 0.58) compared with those who experienced MRD-positive remission (mean, 17.0; SD, 1.41; P = .03) or persistent disease (mean, 12.2; SD, 6.43; P = .02). Additionally, those who achieved MRD-negative remission early following induction therapy had a significantly lower number of clones compared with patients who had residual MRD prior to beginning allo-SCT (mean, 19.5; SD, 2.12; P = .05).
Investigators observed an MRD-negative remission rate of 84% following allo-SCT. Additionally, only 2% and 10% of patients had persistent disease or MRD-positive remission, respectively, at the time of first disease status assessment following allo-SCT. The median duration of MRD clearance was 35.5 months (HR, 2.70; 95% CI, 1.09-6.63; P = .03) for patients with MRD-positive disease and 8.1 months (HR, 7.88; 95% CI, 2.67-23.06; P <.001) for those with persistent disease.
With a median follow-up of 29.9 months, median OS was not reached for patients with early MRD clearance after induction therapy and those who converted from MRD-positive remission to MRD-negative remission with additional therapy before allo-SCT. The median OS was 36.6 months (95% CI, 18.8-not reached [NR]) for patients who had early MRD clearance or conversion and 11.8 months (95% CI, 8.8-NR) for those with persistent disease.
“Our data argue for future strategies tailored to patients with adverse molecular features and high clonal diversity who are currently unlikely to achieve AML MRD clearance,” the study authors stated.
Stahl M, Derkach A, Farnoud N, et al. Molecular predictors of immunophenotypic measurable residual disease clearance in acute myeloid leukemia. Am J Hematol. 2023;98:79-89. doi:10.1002/ajh.26757